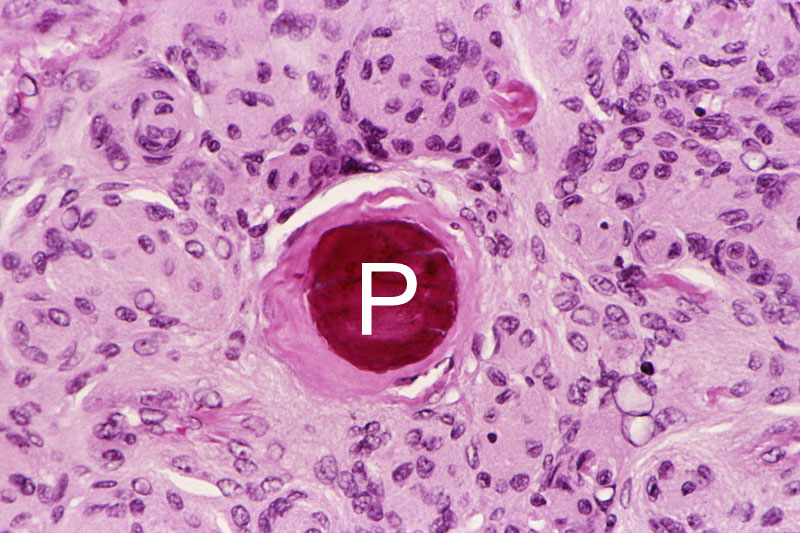

Гистология и гематоксилиновые шары: образовательные иллюстрации

Раздел: Фотопанорама